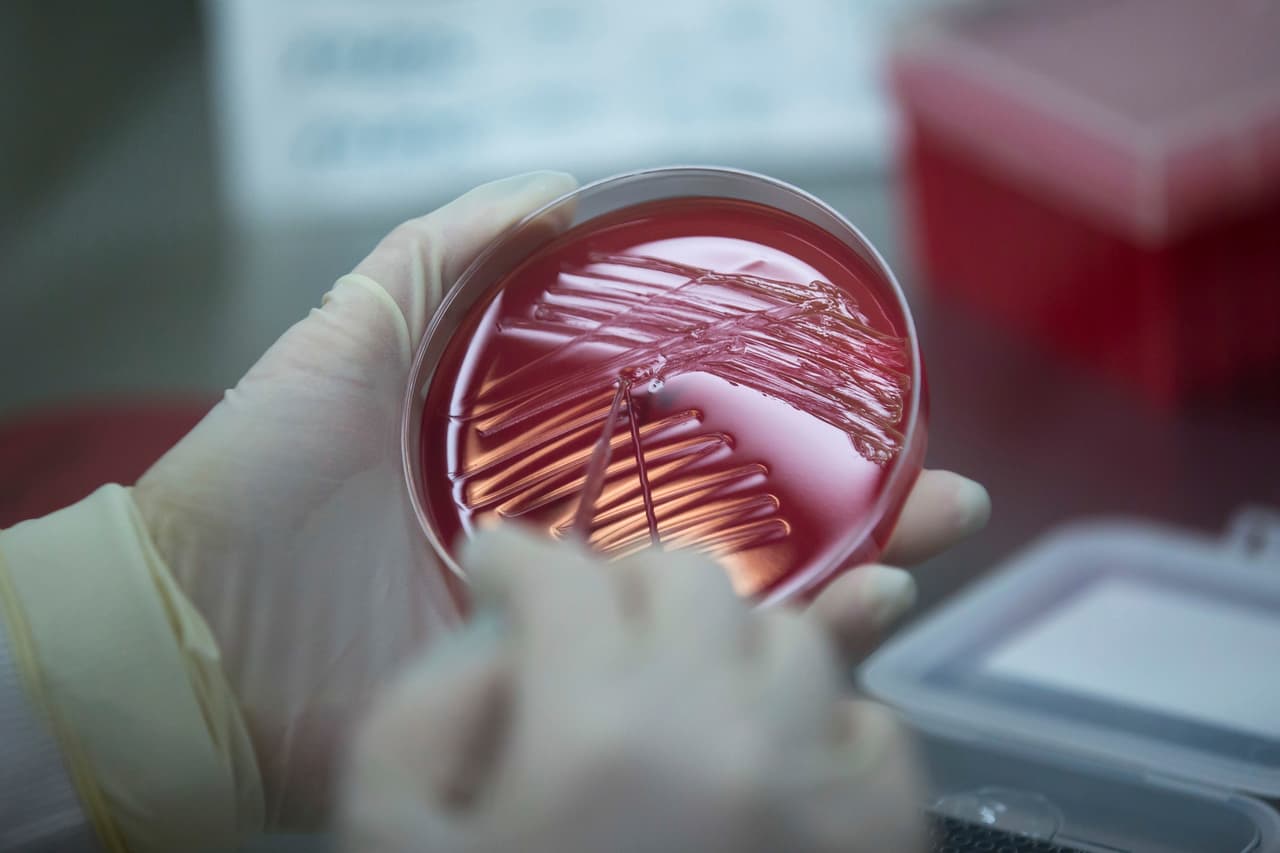
¿Qué es? Es un metal tóxico que se usa en los combustibles fósiles y se puede combinar con otros metales para producir aleaciones que sirven para producir baterías, municiones y otros productos, explican los Centers for Disease Control. La 
<a href="http://www.who.int/mediacentre/factsheets/fs379/es/">OMS</a> advierte que también se utiliza en muchos otros productos como esmaltes cerámicos, artículos de joyería y juguetes, y en algunos productos cosméticos y medicamentos tradicionales.

La dermatóloga de Irvine, California, Yue P. Yu, ha sido señalada por su esposo, el radiólogo Jack Chen, como la responsable de intentar envenenarlo.
Dermatóloga de Irvine habría intentado matar a su esposo envenenando sus bebidas con Drano
La víctima decidió poner cámaras escondidas en su casa para confirmar su teoría de que estaba siendo envenenado por su esposa. Tras reunir las pruebas llamó a la policía y ha solicitado el divorcio, órdenes de restricción y la custodia exclusiva de sus dos hijos.
De acuerdo con la información que Chen, de 53 años, dio al tribunal y fue obtenida por The NY Post, Yu “trató de matarlo” vertiendo Drano en sus bebidas, por lo que fue detenida.
Chen dijo que, su esposa de 45 años con la que estuvo por 10 años, envenenó sus bebidas “al menos tres veces durante el mes de julio”.
En su declaración ante el tribunal, Chen dijo que sufrió dos úlceras estomacales, gastritis e inflamación en el esófago por el presunto envenenamiento.
Jack Chen también dijo que su esposa - quien también se hace llamar Emily, según se ve en su cuenta de LinkedIn - y su suegra, abusaron verbal, física y emocionalmente de él y de sus dos hijos, de 8 y 7 años, por lo que recibió una orden de restricción temporal contra su esposa.
El tribunal también ordenó a Yu que se mantuviera al menos a 100 metros de distancia de su hijo y su hija.
¿Cómo se enteró Jack Chen del envenenamiento?
El médico radiólogo dijo en su declaración que comenzó a sospechar de un posible envenenamiento cuando comenzó a sentirse “gravemente enfermo”, por lo que decidió instalar una “cámara de niñera” en su cocina.
En las imágenes de la cámara presentadas ante el tribunal y obtenidas por The NY Post muestran a Yue Yu sosteniendo una gran botella de plástico roja - muy parecida a la del destapa caños marca Drano - y vertiendo su contenido en una taza.
Luego, en otra foto, se puede ver a Chen bebiendo de esa taza.
De acuerdo con la defensa de Chen, tienen pruebas de video de que Yu usó Drano en la bebida de su esposo los días 11 y 18 de julio.
Pero Jack Chen afirma en la presentación judicial que ya se había sentido enfermo durante algunos meses antes de informar a la policía de Irvine, el pasado jueves 4 de agosto, sobre el presunto envenenamiento.
“Este video (del 18 de julio) me muestra tomando un sorbo de mi limonada aún caliente, cubriendo mi vaso con papel film y luego Emily sacando el Draino (sic) de debajo del fregadero, quitando la tapa para verter el Drano, y luego reemplazar el celofán y volver a colocar el Drano (sic)”, dijo Chen en su declaración.
Jack Chen pidió el divorcio a Yue P. Yu y la custodia exclusiva de los niños
Además del presunto intento de envenenamiento, Jack Chen dijo en su declaración que 'Emily' Yu y su suegra, lo han maltratado a él y a sus hijos, por lo que solicitó el divorcio y la custodia exclusiva de los niños el viernes 5 de agosto.
“Actualmente ella minimiza mi existencia diciéndoles a los niños frente a mí, 'díganle' que haga algo sin dirigirse a mí. Haría que los niños me dijeran que hiciera tareas domésticas para ella”, escribió Chen en su declaración.
“La crianza de Emily, si se puede llamar así, gira en torno a gritar, insultar, abusar verbalmente, golpear, empujar, tirar y ser emocionalmente abusivo”, añadiendo que su esposa supuestamente privaba a los niños del sueño, a menudo los hacía llorar y los insultaba.
"Cuando Emily se frustra y les grita a los niños, suele usar una frase china que se traduce como '¡muéranse!'. También les dice a los niños: 'su cabeza tiene un problema', 'su cabeza está enferma', 'maldito idiota', 'estúpido de mierda' y 'quítate de en medio'”.
Al momento, no se han presentado cargos contra Yue P. Yu, tras ser puesta en libertad el viernes por la noche después de pagar una fianza de $30,000 dólares, según los registros del alguacil del condado de Orange.
David Wohl, abogado de Yu, dijo a The NY Post que su clienta “absoluta e inequívocamente niega haber envenenado a su esposo y abusado de él y sus hijos”.
“La única respuesta que tengo a eso es que (Chen) está tratando desesperadamente de obtener una ventaja en el divorcio”, dijo Wohl.
Sin embargo, Steven Hittelman, abogado de Chen, dijo que están cooperando con los investigadores y han entregado el video a la oficina del fiscal del condado de Orange.
“Comenzó a notar que algo andaba mal en marzo o abril, y cuando se hizo más pruebas médicas, comenzó a tener síntomas bastante significativos”, dijo Hittelman. “Fue entonces cuando comenzó a equiparar los sabores químicos con los síntomas que estaba experimentando”.

![Si crees que has estado en riesgo de envenenamiento con plomo puedes buscar más información llamando al teléfono 1 (800) 424-LEAD [5323].](/_next/image?url=https%3A%2F%2Fst1.uvnimg.com%2F26%2F4c%2Fc4dfc7bb41cc88a9a3782ddc1831%2Fistock-492805660.jpg&w=1280&q=75)